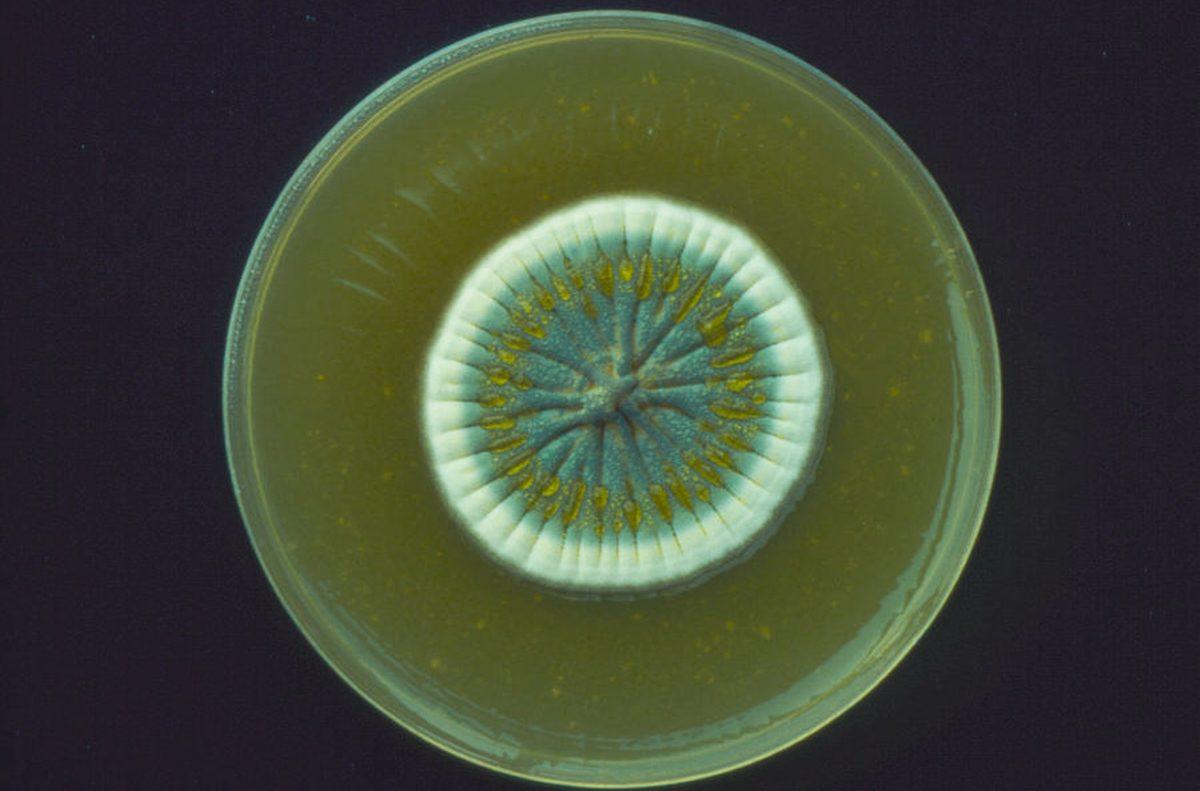

İnsülin, aspirin, morfin, kuduz aşısı ve çiçek aşısı gibi buluşlar, biz insanların yaşam kalitesini ve süresini arttıran önemli tıbbi gelişmelerdi. Hiç şüphesiz bugün dünyanın en çok kullanılan antibiyotiği olan penisilin de yine tıp dünyasındaki en önemli buluştu.
Bugün sizlerle beraber penisilinin nasıl ve kim tarafından keşfedildiğini, ne işe yaradığı gibi konulara değineceğiz.
Dağınık bir odada penisilinin keşfi

Penisilin, 1928 yılında İskoç bilim insanı Alexander Fleming tarafından keşfedildi. Tıpkı Fleming gibi daha pek çok bilim insanının yıllarca penisilyum üzerine çalıştığını ifade edebiliriz fakat aradıkları şeyi tam olarak bulabildiklerinden söz edemeyiz.
Penisilyum üzerine çalışan bilim insanlarından biri olan Fleming, son derece dağınık çalışan biriydi. Günlerce dağınık çalışır, birkaç saatte çalışma ortamını düzenler ve 5 dakika sonra yine tüm düzenini kaybederdi. Hiç kimse bu dağınıklığın, insanlığın kaderinin değiştiren penisilinin keşfini ve Fleming’e Sir unvanı ve Nobel Ödülü getireceğini tahmin etmemişti.
1927 yılında, dağınık çalışma ortamını düzenlemeye koyulan Fleming; mantarların bazı zararlı bakterileri yok edebildiğini gördü ve çalışmalarını bu yönde yoğunlaştırdı. Bir sene sonra, 1928 yılında penisilini keşfeden Fleming, 1930 yılında öğrencisi Doktor Cecil George Paine ile göz enfeksiyonlarında penisilin kullandı ve başarılı bir sonuç aldı.
Penisilinin halka açılımı

Pek çok önemli buluş gibi penisilin de ilk başta hemen halkın kullanımına açılmadı. Penisilin, 1945 yılına kadar sadece askerî alanda kullanıldı. Özellikle İkinci Dünya Savaşı’nda Müttefik Devletler tarafından kullanılan penisilin, savaşta yaralanan pek çok askerin yaralarına şifa oldu.
Savaş sona erdikten hemen sonra, önce Avustralya hemen ardından da ABD’de halkın kullanımına sunulan penisilin, bugün dünyanın en çok tercih edilen antibiyotiğidir.
Penisilinin kullanım alanları
Penisilyum mantarından üretildiği için Fleming tarafından penisilin olarak adlandırılan ilaç; zatürre, akciğer iltihabı, kulak enfeksiyonları, mesane ve böbrek iltihabı, deri enfeksiyonları, menenjit, şarbon hastalığı, kemik ve eklem iltihapları ile cinsel yolla bulaşan enfeksiyonlar başta olmak üzere daha pek çok hastalığın tedavisinde kullanılmaktadır.
Penisilinin mali yönü ve alerjiler

Penisilin; hem üretim hem de muhafaza yönünden bakıldığında pek çok ilaca göre çok ucuz olarak tabir edilen bir ilaçtır. Bununla birlikte alınan verim de düşünüldüğünde, penisilin ucuz ve etkili bir ilaç olarak ifade edilmektedir.
Enfeksiyonlara karşı çok etkili olup, diğer ilaçlara oranla toksik etkisi daha düşük olan penisilin, bazı kişilerde alerjik reaksiyonlara neden olmaktadır. Yayınlanan bir rapora göre; insanların yaklaşık %1’inin penisiline karşı alerjisi bulunur. Bu %1’lik oranın içindeki ölümcül alerjik reaksiyon oranı ise sadece %0,03^tür.










 Paylaş
Paylaş





 1
1



![Samsung Galaxy S26 modelleri kanlı canlı görüntülendi [Video]](https://imgrosetta.webtekno.com/file/642511/642511-640xauto.jpg)
![Samsung'un Üçe Katlanan Telefonu Galaxy Z TriFold, JerryRigEverything'in Sağlamlık Testine Girdi [Video]](https://imgrosetta.webtekno.com/file/641925/641925-640xauto.jpg)


